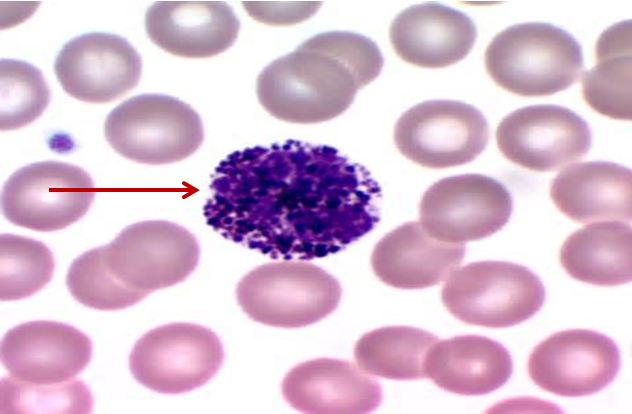
<p>Tế bào gì ?</p>
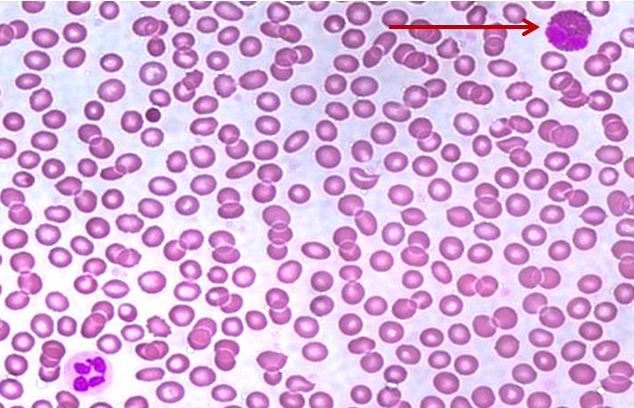
<p>Tế bào gì ?</p>
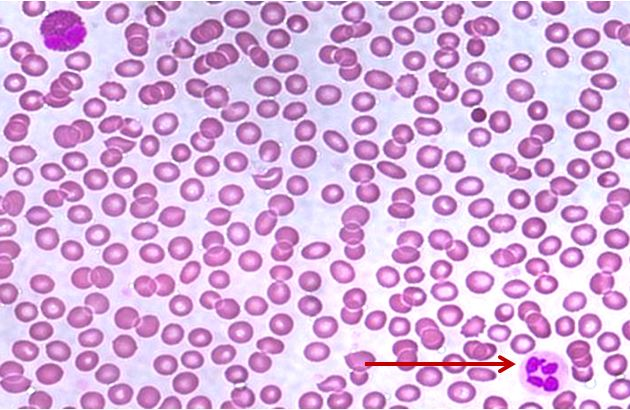
<p>Tế bào gì ?</p>
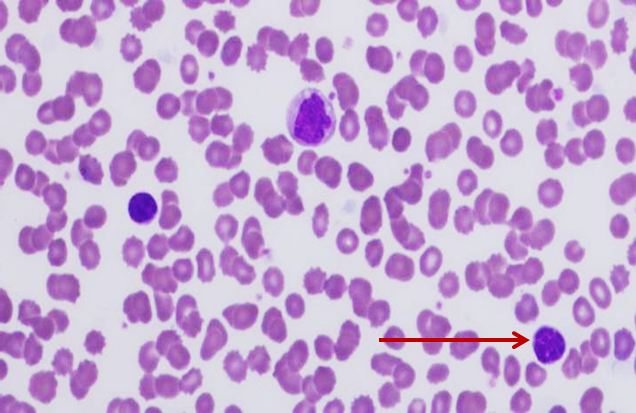
<p>Tế bào gì ?</p>
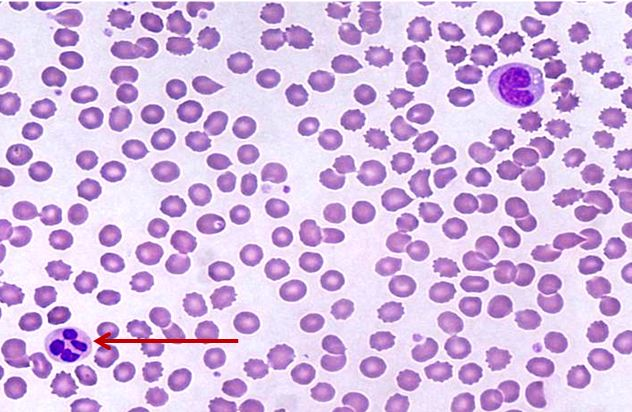
<p>Tế bào gì ?</p>
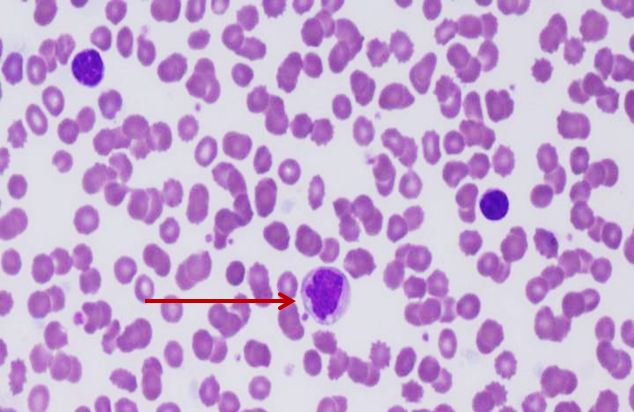
<p>Tế bào gì ?</p>
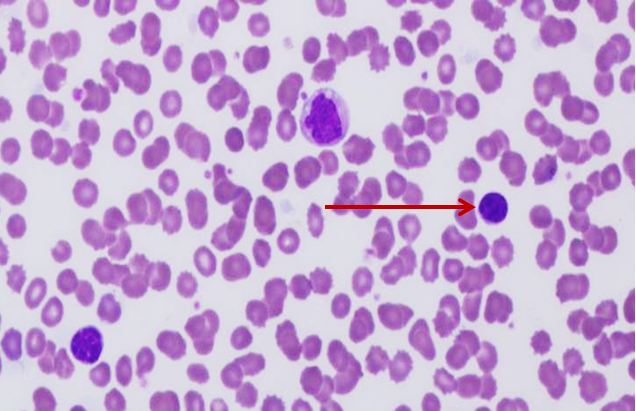
<p>Tế bào gì ?</p>
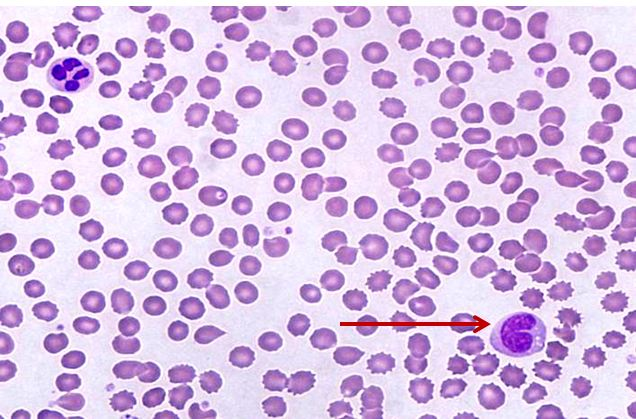
<p>Tế bào gì ?</p>
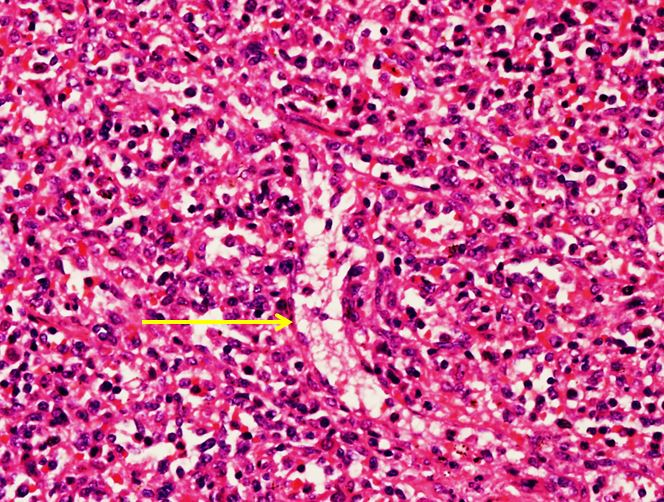
<p>Cấu trúc gì ?</p>

Đề lượng giá
1/169
There's no tags or description
Looks like no tags are added yet.
Name | Mastery | Learn | Test | Matching | Spaced | Call with Kai |
|---|
No analytics yet
Send a link to your students to track their progress
170 Terms
THẬN:
_BM lát đơn
_BM vuông đơn, trụ đơn
_BM đa dạng tầng
DA:
_BM lát tầng sừng hoá
_BM lát đơn, vuông tầng
_Mô liên kết đặc không định hướng
_Tế bào sợi, Nguyên bào sợi, TB nội mô, TB mỡ
HỖNG TRÀNG:
_BM trụ đơn có vi nhung mao
_Mô liên kết thưa
_TB Lympho, TB sợi
DẠ DÀY:
_BM trụ đơn tiết nhầy
_Mô liên kết thưa
_TB lympho, TB sợi, Nguyên bào sợi, tương bào
THỰC QUẢN:
_BM lát tầng không sừng hoá
_BM vuông tầng
KHÍ QUẢN:
_BM trụ giả tầng có lông chuyển
MÔ SỤN:
Đĩa sụn nối
Sụn nghỉ, sụn xếp hàng, sụn phì đại, sụn ngấm calcium
MÔ XƯƠNG:
Tạo cốt bào
Cốt bào
Huỷ cốt bào
Màng trong xương
Màng ngoài xương: lớp sợi, lớp tế bào, bè xương
POLYP MŨI:
Biểu mô trụ giả tầng có lông chuyển (hc hay ko cũng được)
Tương bào
Bạch cầu ưa acid
PHẾT MÁU NGOẠI VI:
Bạch cầu trung tính
Bạch cầu ưa base
Bạch cầu ưa acid
Bạch cầu mono
Bạch cầu lympho
CƠ VÂN:
Cơ vân cắt dọc, cơ vân cắt ngang
Màng quanh bó cơ
Mô trong cơ
CƠ TIM:
Cơ tim cắt dọc, cơ tim cắt ngang
Vạch bậc thang
Khoang Henle
Đĩa nối
HỖNG TRÀNG:
Cơ trơn cắt dọc, cơ trơn cắt ngang
Cơ trơn thành mạch máu
TIỂU NÃO:
Chất xám: lớp phân tử, lớp purkinjie, lớp hạt
Chất trắng
TUỶ SỐNG:
Chất trắng:
Chất xám: Ống nội tuỷ (BM vuông đơn có lông chuyển), Neuron thần kinh, Thể Nissl
DÂY THẦN KINH:
Mô liên kết: Bao bó TK, Bao ngoại TK
Sợi thần kinh: tế bào Schwann, Mô nội TK (Tế bào sợi, tế bào nội mô)
MẠCH MÁU/ ĐỘNG MẠCH:
Lớp áo trong
Lớp áo giữa
Lớp áo ngoài
Màng chun trong
Màng chun ngoài

THỰC QUẢN:
Tầng niêm mạc:
1. Biểu mô: lát tầng không sừng hoá
2. Lớp đệm: ống bài xuất
3. Cơ niêm: không liên tục
Tầng dưới niêm mạc: tuyến nhầy thực quản
DẠ DÀY:
Tầng niêm mạc:
Biểu mô: trụ đơn tiết nhầy
Lớp đệm: tuyến đáy vị
Cơ niêm: liên tục
Tầng dưới niêm mạc: mô liên kết đặc không định hướng
HỖNG TRÀNG:
Tầng niêm mạc:
Biểu mô: trụ đơn có vi nhung mao
Lớp đệm: tuyến Lieberkühn
Cơ niêm: liên tục
Tầng dưới niêm mạc: van ngang
TÁ TRÀNG:
Tầng niêm mạc:
Biểu mô: trụ đơn có vi nhung mao
Lớp đệm: tuyến Lieberkühn
Cơ niêm: không liên tục
Tầng dưới niêm mạc: tuyến Brunner
TUYẾN MANG TAI - TUYẾN DƯỚI HÀM:
Nang nước
Nang nhầy
Nang pha
Ống bài xuất trong tiểu thuỳ
Ống vân
Ống bài xuất gian tiểu thuỳ
TUỴ (1-5: tuỵ ngoại tiết, 6: tuỵ nội tiết):
Nang chế tiết
Tế bào nang tuyến
Tế bào trung tâm nang tuyến
Ống bài xuất trong tiểu thuỳ
Ống bài xuất gian tiểu thuỳ
Tiểu đảo Langerhans
GAN:
Tĩnh mạch trung tâm tiểu thuỳ
Bè Remak (bè gan)
Mao mạch nan hoa
Tế bào Kupffer
Động mạch gan
Tĩnh mạch cửa
Ống mật
PHỔI:
_Đường dẫn khí
Phế quản gian tiểu thuỳ: biểu mô trụ giả tầng có lông chuyển
Tiểu phế quản chính thức: biểu mô trụ đơn có lông chuyển
Tiểu phế quản tận: biểu mô trụ đơn xen kẽ vuông đơn có lông chuyển
_Phần hô hấp:
Tiểu phế quản hô hấp: biểu mô vuông đơn có lông chuyển
Ống phế nang
Túi phế nang
Phế nang: Phế bào I + Phế bào II
DA:
_Biểu bì:
Phân biệt 5 lớp của biểu mô lát tầng sừng hoá
_Chân bì:
Tiểu thể Meissner
Phần chế tiết của tiểu cầu mồ hôi
Phần bài xuất của tiểu cầu mồ hôi
_Hạ bì:
Mô mỡ
Tiểu thể Pacini
CƠ QUAN SINH DỤC NAM:
_Tiêu bản: tinh hoàn
_Ống sinh tinh:
Tinh nguyên bào
Tinh bào
Tiền tinh trùng
Tinh trùng
Tế bào Sertoli
_Lưới tinh hoàn:
Biểu mô vuông đơn
_Tuyến kẽ:
Tế bào Leydig
_Ống mào tinh:
Biểu mô trụ giả tầng có lông giả
CƠ QUAN SINH DỤC NỮ:
_Tiêu bản: buồng trứng, vòi trứng
_Buồng trứng: biểu mô vuông đơn
Nang trứng nguyên thuỷ
Nang trứng sơ cấp
Nang trứng thứ cấp đặc
Nang trứng thứ cấp có hốc
THẬN:
_Vùng vỏ:
Tiểu cầu thận
Ống lượn gần
Ống lượn xa
Phức hợp cận tiểu cầu
Vết đặc
Tế bào cận mạch
Tế bào cận tiểu cầu
_Vùng tuỷ:
Ống góp
Tế bào tối
Tế bào sáng
Quai Henle
CƠ QUAN TẠO HUYẾT VÀ MIỄN DỊCH:
_TUYẾN ỨC:
Vùng trung tâm (vùng tuỷ)
Vùng ngoại vi (vùng vỏ)
Tiểu thể Hassal
_HẠCH BẠCH HUYẾT:
Vỏ xơ
Vách xơ
Dây xơ
Xoang dưới vỏ
Xoang quanh nang
Xoang tuỷ
_LÁCH:
Tuỷ trắng: nang lympho, tiểu động mạch trung tâm
Tuỷ đỏ: xoang tĩnh mạch lách, dây lách (dây Billroth)
Khung chống đỡ: vỏ xơ, bè xơ
CƠ QUAN NỘI TIẾT:
_Tuyến yên:
Thuỳ trước tuyến yên: tế bào ưa acid, tế bào ưa base, tế bào kỵ màu
Thuỳ sau tuyến yên
_Tuyến giáp:
Nang giáp:
Biểu mô vuông
Biểu mô lát đơn (dạng không hoạt động)
Biểu mô trụ đơn (dạng hoạt động mạnh)
Tế bào nang
Chất keo giáp
Không bào tái hấp thu
_Tuyến thượng thận:
Vùng vỏ:
Lớp cung - Lớp bó - Lớp lưới
Vùng tuỷ:

MẮT:
_3 lớp áo của nhãn cầu:
Áo ngoài: củng mạc, giác mạc
Áo giữa: mống mắt, thể mi, màng mạch
Áo trong: lớp tế bào sắc tố, lớp thần kinh
_Tiền phòng, hậu phòng
_Giác mạc:
Biểu mô lát tầng không sừng hoá
Màng Bowman
Nhu mô (lớp đệm)
Màng Descemet
Nội mô giác mạc: biểu mô lát đơn
MÔ RĂNG:
_Răng nhỏ:
Men răng
Nguyên bào men răng
Ngà răng
Chất tiền ngà
Tuỷ răng
_Răng lớn:
Men răng
Ngà răng
_Nha chu nhỏ:
Biểu mô nướu: biểu mô lát tầng sừng hoá
Biểu mô khe nướu: biểu mô lát tầng không sừng hoá
Dây chằng nha chu
Xương ổ răng
Cement
Ngà răng
Ống ngà
_Nha chu lớn:
Men răng
Nguyên bào men răng, nguyên bào ngà
Cement
Ngà răng, chất tiền ngà, tuỷ răng
Dây chằng nha chu, xương ổ răng

Biểu mô gì ?
Biểu mô trụ giả tầng có lông chuyển

Tiêu bản gì ?
Thực quản

Biểu mô gì ?
Biểu mô trụ đơn tiết nhầy

Biểu mô gì ?
Biểu mô trụ đơn có vi nhung mao

Biểu mô gì ?
Biểu mô niệu

Biểu mô gì ?
Biểu mô lát đơn

Biểu mô gì ?
Biểu mô lát đơn

Tiêu bản gì ?
Khí quản (có sụn hyaline)


Biểu mô gì ?
Biểu mô vuông tầng
Ống bài xuất có 2 phần:
_Phần chế tiết: BM tuyến + nhạt màu
_Phần bài xuất: BM vuông tầng + đậm màu

Biểu mô gì ?
Biểu mô vuông tầng (tuyến mồ hôi)

Tế bào gì ?
Nguyên bào sợi

Tế bào gì ?
Tế bào sợi

Cấu trúc gì ?
Mô liên kết thưa (trong lòng vi nhung mao)

Tế bào gì ?
Tế bào sợi

Mô liên kết gì ?
Mô liên kết thưa

Tế bào gì ?
Bạch cầu lympho

Tế bào gì ?
Bạch cầu lympho

Tế bào gì ?
Nguyên bào sợi

Tế bào gì ?
Tương bào

Tế bào gì ?
Tế bào nội mô (trong lòng mạch máu)

Cấu trúc gì ?
Lớp tế bào màng ngoài xương

Cấu trúc gì ?
Sụn ngấm canxi

Cấu trúc gì ?
Sụn phì đại

Cấu trúc gì ?
Lớp sợi màng ngoài xương

Cấu trúc gì ?
Sụn nghỉ

Tế bào gì ?
Tạo cốt bào

Cấu trúc gì ?
Màng trong xương

Tế bào gì ?
Huỷ cốt bào

Cấu trúc gì ?
Sụn xếp hàng

Tế bào gì ?
Cốt bào

Tế bào gì ?
Tương bào

Tế bào gì ?
Bạch cầu ưa acid
Tế bào gì ?
Bạch cầu ưa base

Tế bào gì ?
Bạch cầu ưa base
Tế bào gì ?
Bạch cầu ưa acid
Tế bào gì ?
Bạch cầu trung tính
Tế bào gì ?
Bạch cầu ưa base
Tế bào gì ?
Bạch cầu trung tính
Tế bào gì ?
Bạch cầu mono
Tế bào gì ?
Bạch cầu lympho
Tế bào gì ?
Bạch cầu mono

Cấu trúc gì ?
Cơ tim cắt ngang

Cấu trúc gì ?
Cơ vân cắt ngang

Cấu trúc gì ?
Màng quanh bó cơ

Cấu trúc gì ?
Cơ vân cắt dọc

Cấu trúc gì ?
Khoang Henlé

Tế bào gì ?
Tế bào cơ trơn

Cấu trúc gì ?
Cơ vân cắt ngang


Cấu trúc gì ?
Cơ vân cắt dọc

Cấu trúc gì ?
Cơ trơn cắt ngang

Cấu trúc gì ?
Cơ trơn cắt dọc

Tế bào gì ?
Tế bào schwann

Cấu trúc gì ?
Lớp hạt của chất xám tiểu não

Cấu trúc gì ?
Chất xám tuỷ sống

Cấu trúc gì ?
Bao ngoại thần kinh

Cấu trúc gì ?
Chất trắng tuỷ sống

Biểu mô gì ?
Biểu mô vuông đơn có lông chuyển


Cấu trúc gì ?
Chất trắng tiểu não

Tế bào gì ?
Tế bào sợi

Cấu trúc gì ?
Chất xám tuỷ sống

Cấu trúc gì ?
Lớp áo giữa - mạch máu

Cấu trúc gì ?
Dây tuỷ

Cấu trúc gì ?
Tiểu động mạch trung tâm

Cấu trúc gì ?
Tiểu thể Hassal (không có tế bào nội mô lót lòng, bản chất là tế bào lưới thoái hoá tạo thành)

Tiêu bản gì ?
Lách (thấy có tuỷ đỏ + tuỷ trắng)

Cấu trúc gì ?
Dây xơ

Cấu trúc gì ?
Mạch máu

Cơ quan gì ?
Hạch bạch huyết

Cấu trúc gì ?
Xoang dưới vỏ
Cấu trúc gì ?
Xoang tĩnh mạch lách

Tiêu bản gì ?
Tuyến ức

Cấu trúc gì ?
Cơ trơn cắt dọc

Tầng gì ? - Tiêu bản gì ?
Tầng dưới niêm mạc dạ dày

Biểu mô gì ?
Biểu mô vuông tầng

Cấu trúc gì ?
Đám rối thần kinh Auerbach

Cấu trúc gì ?
Đám rối thần kinh Auerbach

Tầng gì ? - Tiêu bản gì ?
Tầng cơ dạ dày

Tế bào gì ?
Tế bào chính

Tầng gì ? - Tiêu bản gì ?
Tầng dưới niêm mạc thực quản

Tế bào gì ?
Tế bào viền hoặc tế bào thành

Đoạn nào của ống tiêu hoá ?
Tá tràng

Cấu trúc gì ?
Mạch máu

Tế bào gì ?
Tế bào trung tâm nang tuyến

Cấu trúc gì ?
Ống mật

Cơ quan gì ?
Tuỵ (có tế bào trung tâm nang tuyến)

Tiêu bản gì ?
Tuyến nước bọt

Cấu trúc gì - Tiêu bản gì ?
Ống bài xuất trong tiểu thuỳ của tuỵ


Cơ quan gì ?
Gan (có tĩnh mạch trung tâm tiểu thuỳ)